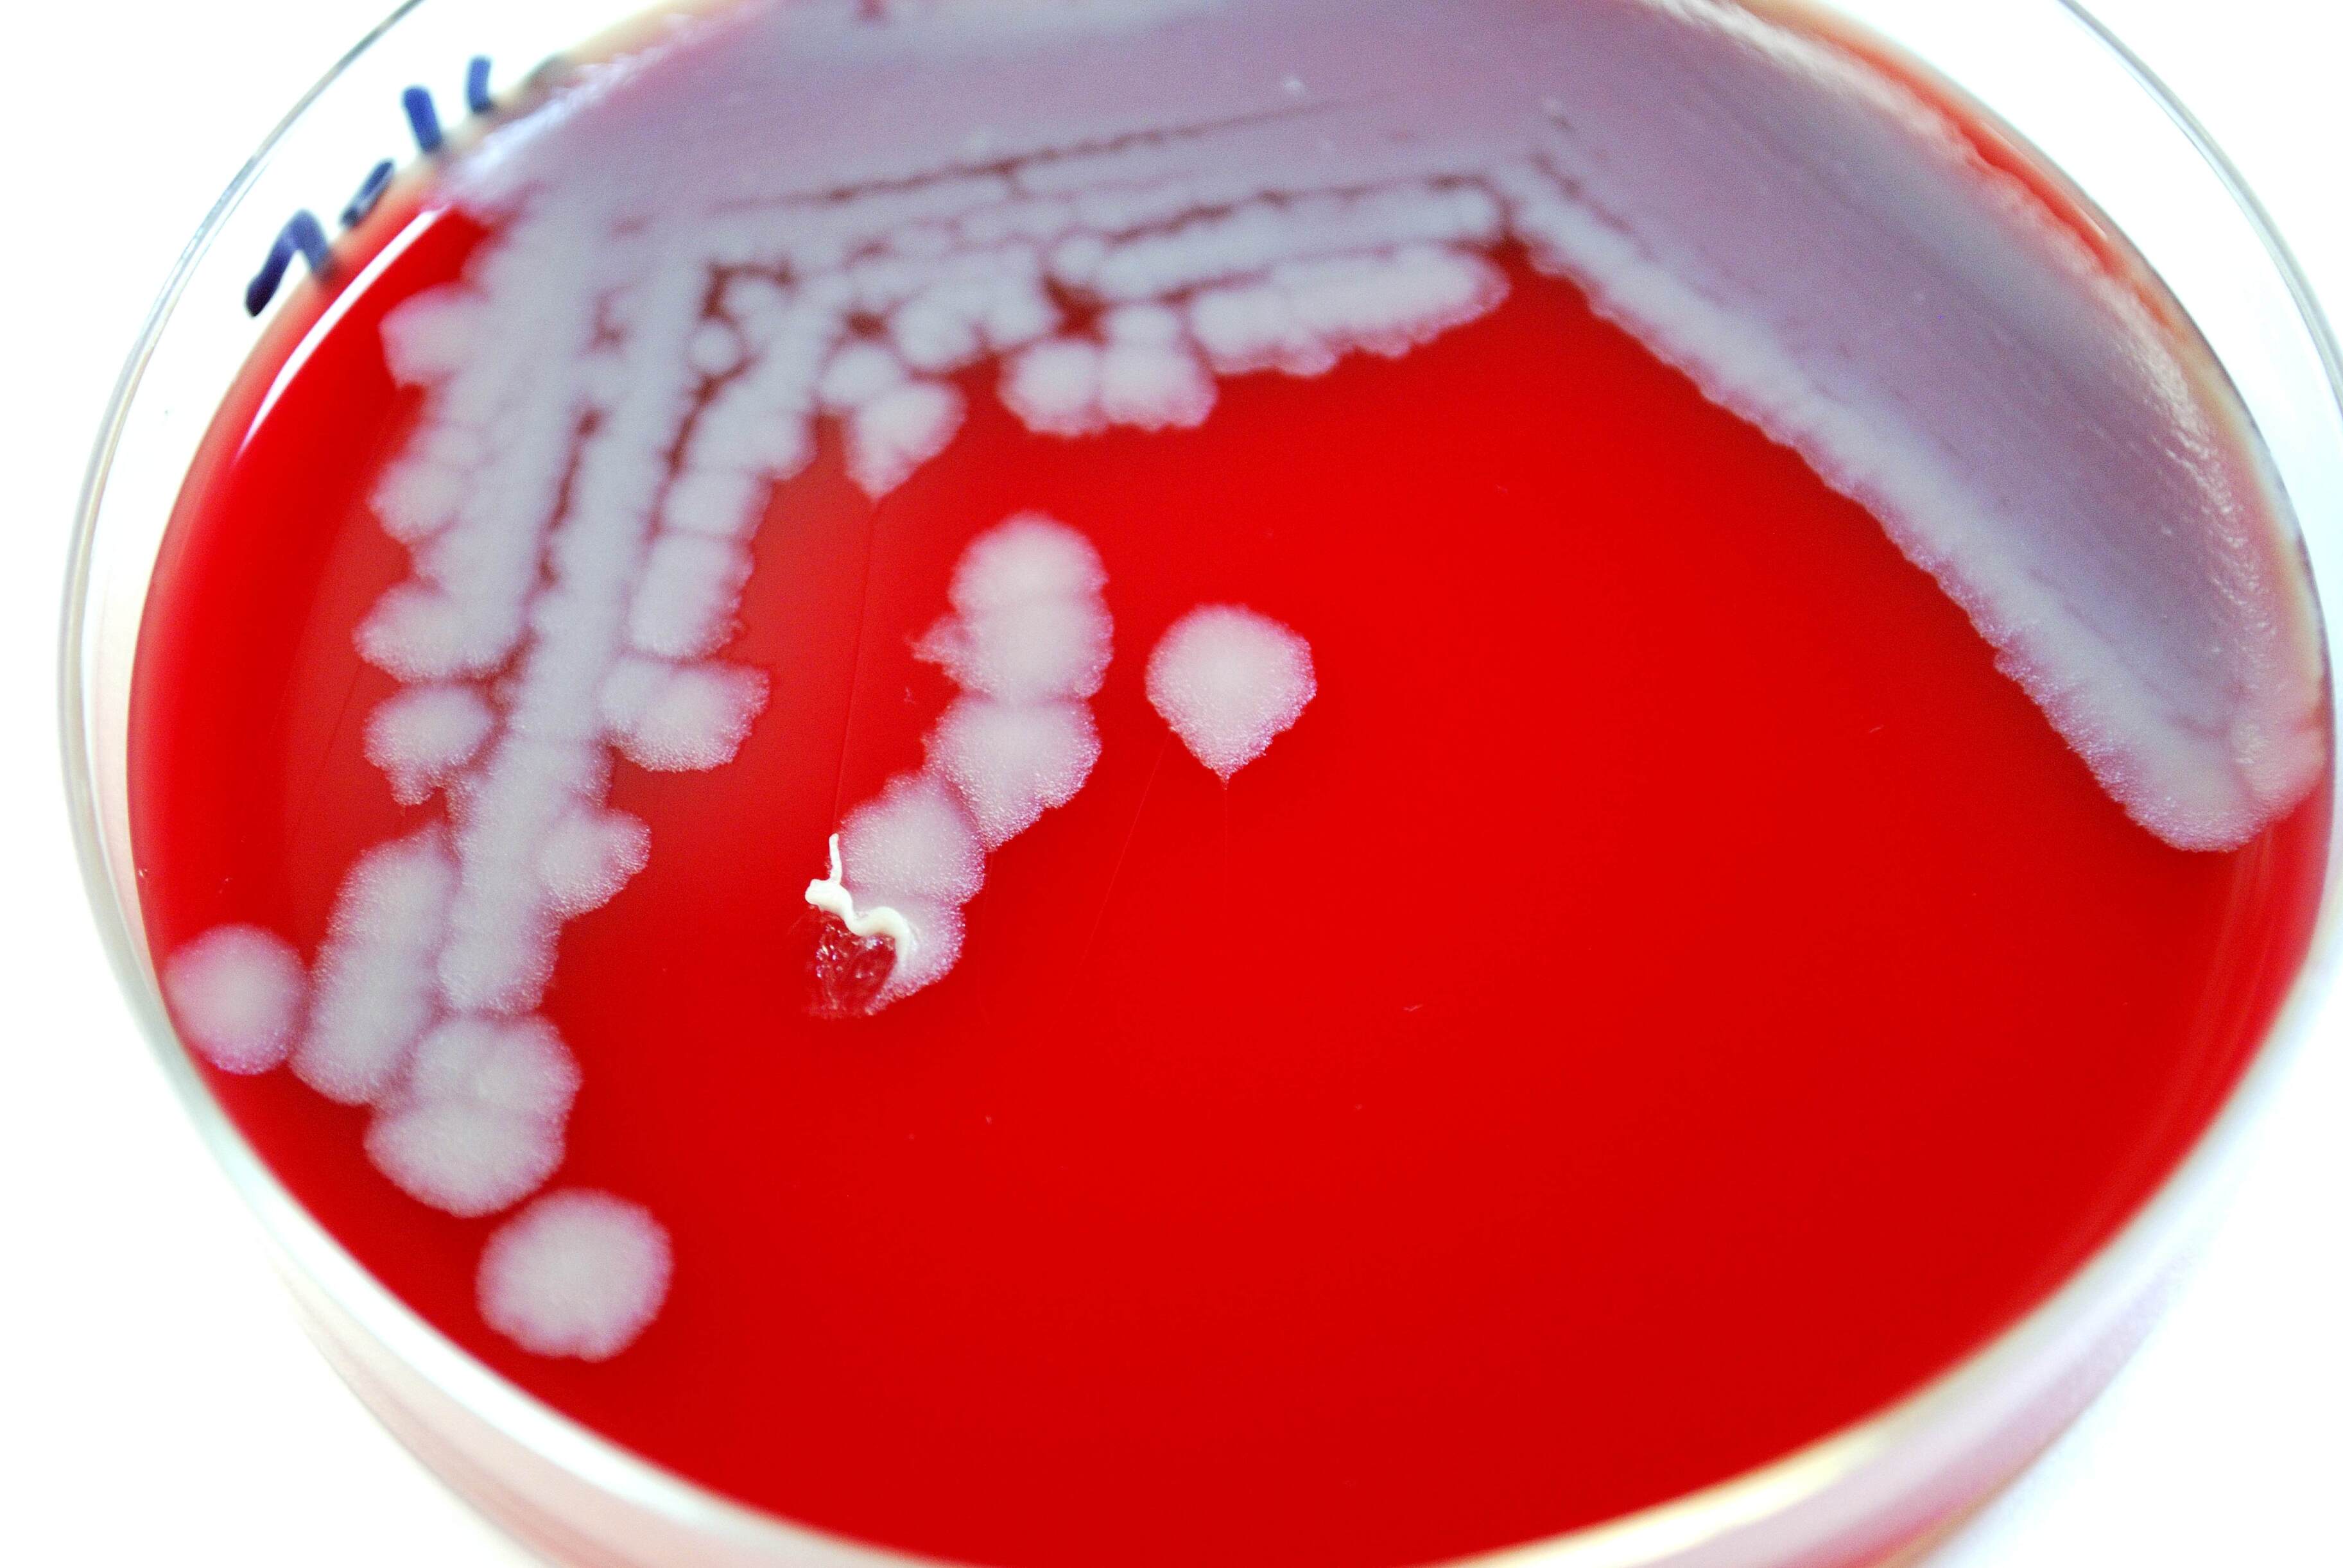

Проявляется сибирская язва в зависимости от того, как заразился больной — через кожу, желудочно-кишечный тракт или дыхательные пути, пояснила врач Екатерина Серебренникова.
В зависимости от формы сибирская язва у человека может иметь разные симптомы, рассказала врач общей практики компании «Доктор рядом» Екатерина Серебренникова.
Рискуют заразиться главным образом тем, кто работает с не вакцинированными от заболевания домашними животными: чаще всего людям заболевание передается контактным путем — через кожу.
На ней появляются характерные поражения — папулы. Затем на их месте возникает черный струп. Болезнь может сопровождаться увеличением лимфоузлов, тошнотой, рвотой, лихорадкой. Врач подчеркивает, что именно кожная форма сибирской язвы передается от человека к человеку наиболее легко.
Хоть и редко, признает Серебренникова, но заболевание может передаваться еще двумя путями — и проходит весьма тяжело, вплоть до смерти.
При приеме в пищу зараженного — и неправильно обработанного — мяса бацилла может привести к язвам, кровотечению, перфорации кишечника. У больного начинается тошнота, его рвет, в стуле наблюдается кровь
Однако особенно тяжело сибирская язва протекает, если человек вдохнул ее споры. Легочная форма происходит с кашлем и лихорадкой.